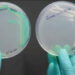
Hospitales al sur de Florida en alerta por hongo potencialmente letal

(22 de marzo del 2023. El Venezolano).- Al menos cuatro muertos y siete heridos dejó un masivo ataque con drones lanzado la madrugada de este miércoles por Rusia contra la capital ucraniana, según un balance preliminar publicado por la Administración Militar de la Ciudad de Kiev en su canal de Telegram.
Las autoridades informaron también que una infraestructura civil habría resultado dañada en el ataque, que habría provocado un incendio controlado por los bomberos “a las 5.50″ de la madrugada, hora local.
“Las unidades del Servicio Público de Emergencias, la Policía Nacional y los demás servicios de emergencias competentes están trabajando en el lugar de los hechos. Las víctimas reciben la asistencia necesaria”, agrega el mensaje de la Administración Militar de Kiev, reseñó Infobae.
Las defensas antiaéreas ucranianas interceptaron 16 de los 21 drones Shahed-136 de fabricación iraní que Rusia lanzó contra Kiev y las regiones de Zhytomyr y Khmelnytsky, al oeste de la capital.
“Todos los objetivos en el espacio aéreo alrededor de Kiev fueron destruidos por nuestras fuerzas de defensa aérea; según la información de la que disponemos en este momento, sin víctimas ni destrucción” de infraestructuras, dice la nota de la Administración Militar de la capital, publicada en Telegram.
Desde que Rusia empezó a lanzar oleadas de ataques periódicas con drones y misiles contra el sistema eléctrico y otras infraestructuras críticas ucranianas, las autoridades de Kiev han logrado mejorar sus sistemas antiaéreos gracias, en parte, al envío de material militar occidental.
Pese a que Ucrania ha logrado en gran medida proteger y reparar su sistema energético, estos ataques rusos siguen poniendo en riesgo a la población civil y el pasado 9 de marzo se cobraron la vida de 9 personas en varios puntos de Ucrania.